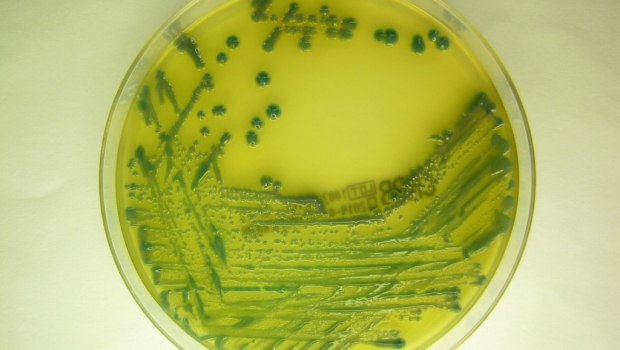

|

|
Live εικόνα Αθήνας από το Αστεροσκοπείο Πεντέλης
 Νεφώσεις |
|
|
| pentelikonews.gr |
Προσαρμοσμένη αναζήτηση

|
|
Εξιτήριο πήρε ο κτηνοτρόφος που κατέρρευσε αποχαιρετώντας με δάκρυα τα 450 πρόβατά του
Ημερομηνία: 7/12/2025, 16:24 - Εμφανίσεις: 32 
Στο σπίτι του αναρρώνει ο κτηνοτρόφος από το Μικρό Μοναστήρι Θεσσαλονίκης, που κατέρρευσε όταν είδε το κοπάδι του να θανατώνεται λόγω των μέτρων για την ευλογιά των προβάτων. «Οι γιατροί μάς είπαν να μην εκνευρίζεται, να μην ταράζεται, να μην συγχίζεται. Πέρασε εγκεφαλικό», δήλωσε η γυναίκα του. Ο άντρας της νοσηλεύτηκε στο Νοσοκομείο Γιαννιτσών. Λίγες ώρες πιο νωρίς είχε αποχαιρετήσει με δάκρυα στα μάτια 450 καθαρόαιμα πρόβατα, κάτι που του προκάλεσε τεράστια θλίψη και κατέρρευσε.googletag.cmd.push(function() { googletag.display("300x250_m1"); }); «Πρώτα η οικογένεια και μετά όλα τα άλλα. Είναι όλη αυτή η κατάσταση από τις 6 του μήνα (σ.σ. στενάχωρη και στρεσογόνα) πολύ ψυχοφθόρα. Αυτό που περνάμε εμείς, καλύτερα να μην το περιγράψω», συμπλήρωσε η ίδια μιλώντας στο STAR. Ο κτηνοτρόφος εκτρέφει εδώ και δεκαετίες πρόβατα της ντόπιας ιστορικής φυλής Ρουμλουκίου – τα τελευταία καθαρόαιμα στην περιοχή. Μοιράστηκε τις δυσκολίες του να φροντίζει ζώα, ιδιαίτερα σε μια εποχή που πολλά θανατώνονται εξαιτίας της ευλογιάς. «Είναι σαν να μας σκοτώνουν τα παιδιά μας ένα-ένα μπροστά μας», είχε πει λίγο πριν τη θανάτωση των προβάτων.document.addEventListener("DOMContentLoaded", function () {lazym2();}); Ο ίδιος, η σύζυγός του και τα παιδιά τους μεγάλωσαν δίπλα στα ζώα και τα φρόντιζαν καθημερινά. «Τα φύλαξα από την πείνα και τους λύκους, από τα πάντα τα φύλαξα. Όταν θα φύγουν τα πρόβατά μου, κάνετε ό,τι θέλετε», λέει με λυγμούς, επισημαίνοντας: «Εγώ δεν γονάτισα ποτέ, δεν δούλεψα ποτέ για άλλον. Αυτό το φονικό, εγώ είμαι αθώος, καθαρός, είμαι καθαρός από αυτό το φονικό, εγώ τα φύλαξα. Επιθυμώ να κάνω το βίντεο για ανάμνηση. Εγώ δεν έχω κλάψει ποτέ στη ζωή μου, δεν έχω γονατίσει». Δείτε το συγκλονιστικό βίντεο:... Πηγή/Περισσότερα: in.gr
|
DRONE VIDEOS
Drone videos από πολλές περιοχές της Ελλάδας.
Τα πιο πρόσφατα: · Θεσσαλονίκη · Καλαμάτα · Λουτράκι · Λίμνη Στράτου · Αγρίνιο · Τρίκαλα · Μετέωρα » Περισσότερα |

Ειδήσεις από το Αθηναϊκό Πρακτορείο Ειδήσεων